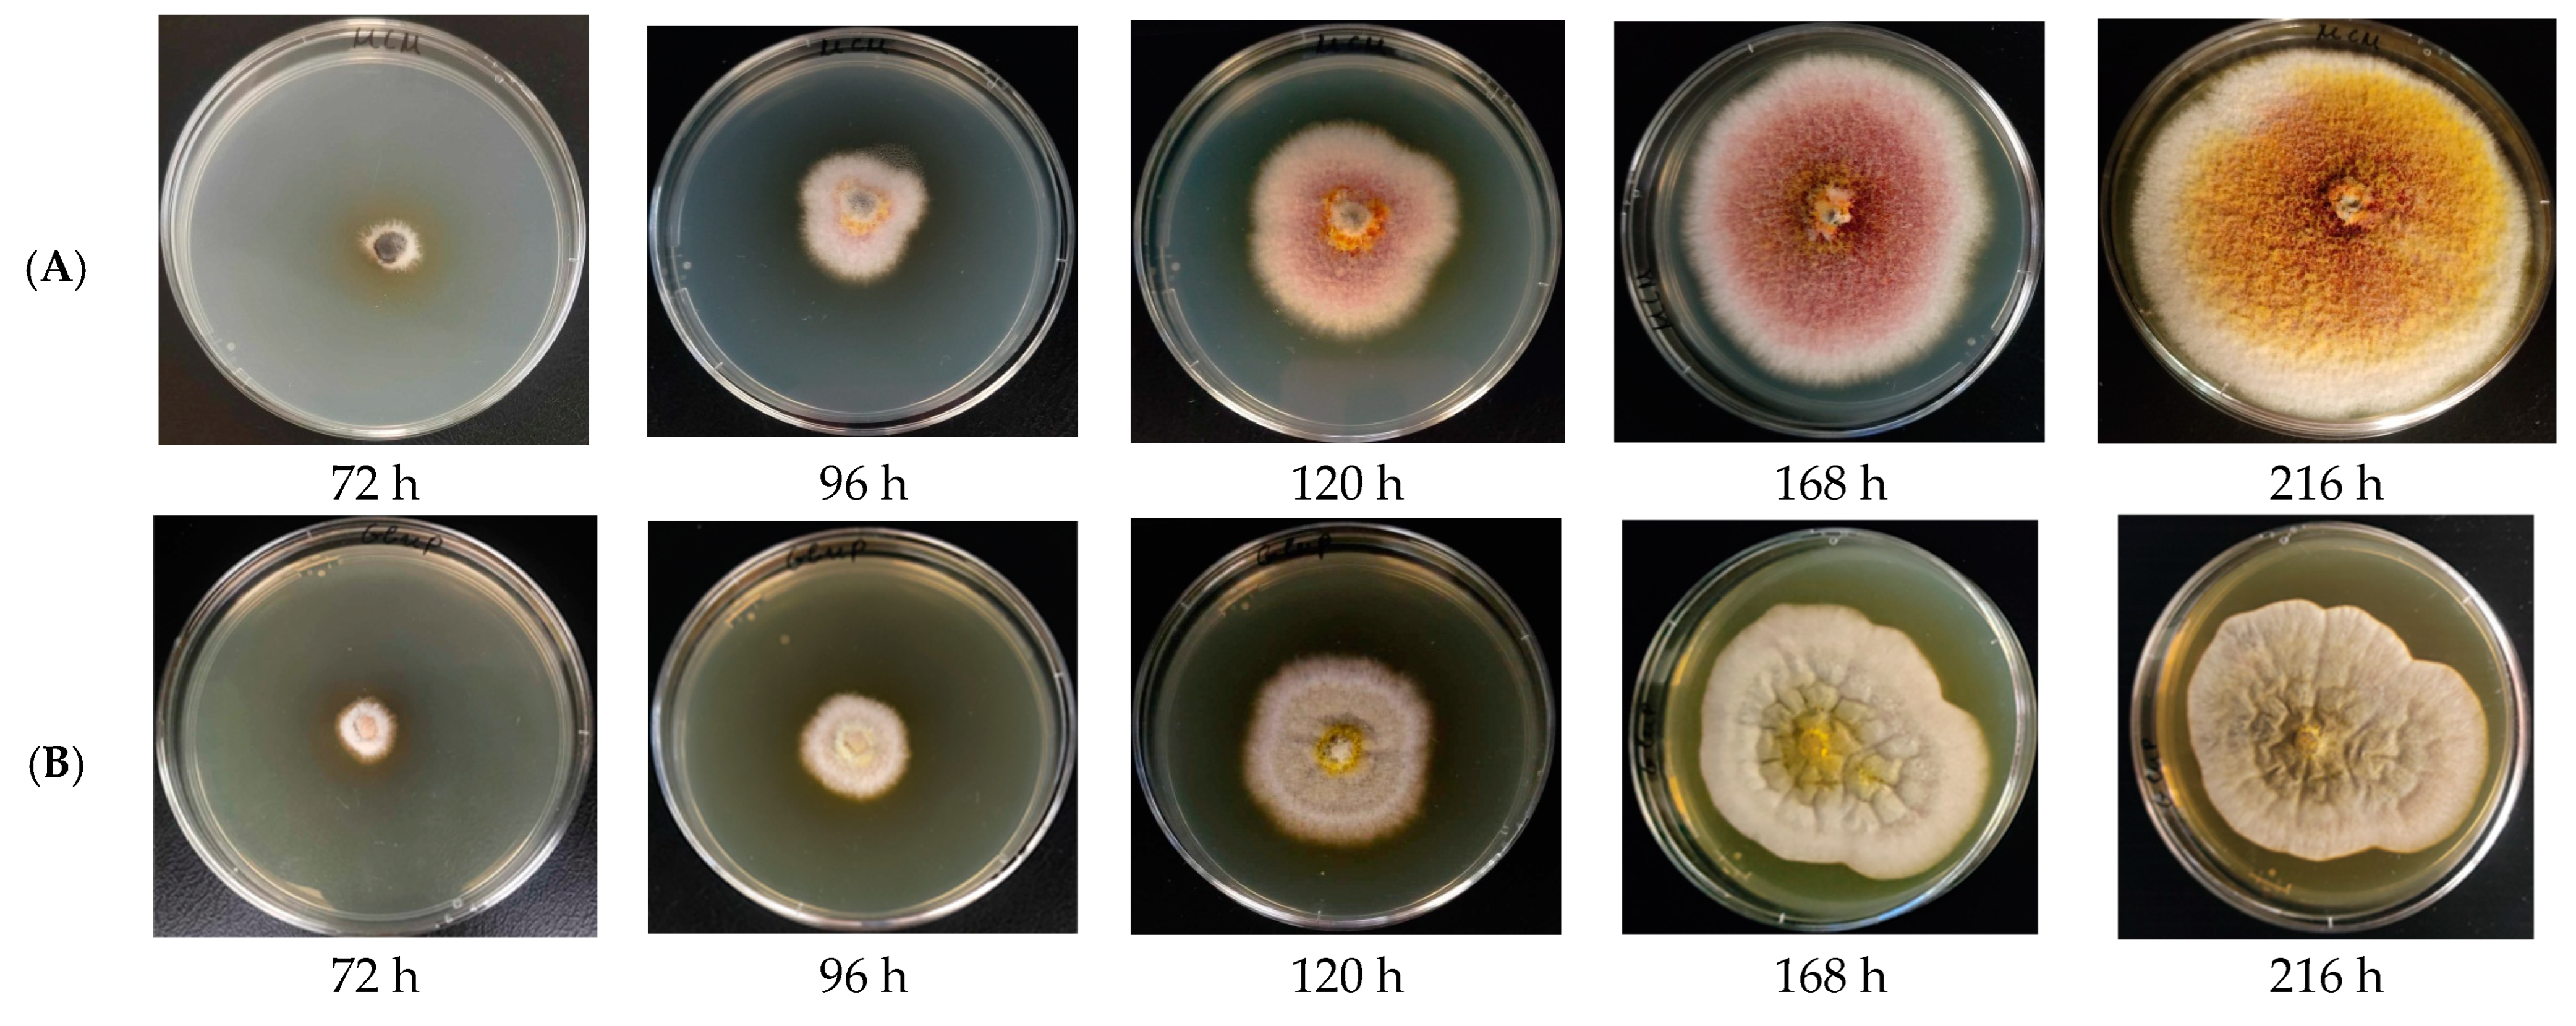
Agriculture 14 02179 g003

Growth Kinetics Modeling and Evaluation of Antiphytopathogenic Activity of Newly Isolated Fungicolous Epicoccum nigrum Associated with Dryad’s Saddle (Polyporaceae)
Abstract
1. Introduction
2. Materials and Methods
2.1. Fungal Isolation, Cultivation, and Morphological Characterization
2.2. Molecular Identification by ITS1-5.8S-ITS2 rRNA Gene Sequence Analysis
2.3. Phlylogenetic Analysis
2.4. Cultivation and Modeling of the Kinetics of the Process
2.5. Submerged Cultivation of E. nigrum
2.6. Antiphytopathogenic Activity
2.7. Statistical Analysis
3. Results and Discussion
3.1. Isolation and Identification of Unknown Fungal Isolate
3.2. Phylogenetic Analysis
3.3. Morphological Characterization
3.4. Modeling of the Kinetics of the Process
3.5. Antiphytopathogenic Activity
4. Conclusions
Author Contributions
Funding
Institutional Review Board Statement
Data Availability Statement
Conflicts of Interest
References
- Maurice, S.; Arnault, G.; Nordén, J.; Botnen, S.S.; Miettinen, O.; Kauserud, H. Fungal sporocarps house diverse and host-specific communities of fungicolous fungi. ISME J. 2021, 15, 1445–1457. [Google Scholar] [CrossRef] [PubMed]
- Sucharzewska, E.; Ejdys, E.; Kubiak, D. Fungicolous fungi on microscopic fungi parasitic to the vegetation of the urban environment. Acta Mycol. 2023, 58, 1–9. [Google Scholar] [CrossRef]
- Sun, J.-Z.; Liu, X.-Z.; McKenzie, E.H.C.; Jeewon, R.; Liu, J.-K.J.; Zhang, X.-L.; Zhao, Q.; Hyde, K.D. Fungicolous fungi: Terminology, diversity, distribution, evolution, and species checklist. Fungal Divers. 2019, 95, 337–430. [Google Scholar] [CrossRef]
- Fatima, N.; Ismail, T.; Muhammad, S.; Jadoon, M.; Ahmed, S.; Azhar, S.; Mumtaz, A. Epicoccum sp., An emerging source of unique bioactive metabolites. Acta Pol. Pharm. Drug Res. 2016, 73, 13–21. [Google Scholar]
- Fávaro, L.C.d.L.; Sebastianes, F.L.d.S.; Araújo, W.L. Epicoccum nigrum P16, a Sugarcane Endophyte, Produces Antifungal Compounds and Induces Root Growth. PLoS ONE 2012, 7, e36826. [Google Scholar] [CrossRef] [PubMed]
- Ali, S.A.-B.; Abdelmoaty, H.; Ramadan, H.; Salman, Y. The endophytic fungus Epicoccum nigrum: Isolation, molecular identification and study its antifungal activity against phytopathogenic fungus Fusarium solani. J. Microbiol. Biotechnol. Food Sci. 2024, 13, e10093. [Google Scholar] [CrossRef]
- Wen, J.; Okyere, S.K.; Wang, S.; Wang, J.; Xie, L.; Ran, Y.; Hu, Y. Endophytic Fungi: An Effective Alternative Source of Plant-Derived Bioactive Compounds for Pharmacological Studies. J. Fungi 2022, 8, 205. [Google Scholar] [CrossRef]
- Li, Q.; Chen, C.; Penttinen, P.; Xiong, C.; Zheng, L.; Huang, W. Microbial diversity associated with Tricholoma matsutake fruiting bodies. Microbiology 2016, 85, 531–539. [Google Scholar] [CrossRef]
- Zhang, Y.; Liu, S.; Che, Y.; Liu, X. Epicoccins A–D, epipolythiodioxopiperazines from a Cordyceps-colonizing isolate of Epicoccum nigrum. J. Nat. Prod. 2007, 70, 1522–1525. [Google Scholar] [CrossRef]
- Wangun, H.V.K.; Dahse, H.M.; Hertweck, C. Epicoccamides B–D, glycosylated tetramic acid derivatives from an Epicoccum sp. associated with the tree fungus Pholiota squarrosa. J. Nat. Prod. 2007, 70, 1800–1803. [Google Scholar] [CrossRef]
- Braga, R.M.; Padilla, G.; Araújo, W.L. The biotechnological potential of Epicoccum spp.: Diversity of secondary metabolites. Crit. Rev. Microbiol. 2018, 44, 759–778. [Google Scholar] [CrossRef] [PubMed]
- Wright, A.D.; Osterhage, C.; König, G.M. Epicoccamide, a novel secondary metabolite from a jellyfish-derived culture of Epicoccum purpurascens. Org. Biomol. Chem. 2003, 1, 507–510. [Google Scholar] [CrossRef] [PubMed]
- Yajima, A.; Kawajiri, A.; Mori, A.; Katsura, R.; Nakada, T. Total synthesis of epicoccamides A and D via olefin cross-metathesis. Tetrahedron Lett. 2014, 55, 4350–4354. [Google Scholar] [CrossRef]
- Randrianjatovo, I.; Girbal-Neuhauser, E.; Marcato-Romain, C.E. Epicocconone, a sensitive and specific fluorescent dye for in situ quantification of extracellular proteins within bacterial biofilms. Appl. Microbiol. Biotechnol. 2015, 99, 4835–4844. [Google Scholar] [CrossRef]
- Christova, P.; Slavov, S. Epicoccum nigrum—Isolation, characterization and potential for biological control of Botrytis cinerea. Bulg. J. Agric. Sci. 2021, 27, 693–698. [Google Scholar]
- Alcock, A.; Elmer, P.; Marsden, R.; Parry, F. Inhibition of Botrytis cinerea by epirodin: A secondary metabolite from New Zealand isolates of Epicoccum nigrum. J. Phytopathol. 2015, 163, 841–852. [Google Scholar] [CrossRef]
- Bhuiyan, S.A.; Ryley, M.J.; Galea, V.J.; Tay, D. Evaluation of potential biocontrol agents against Claviceps africana in vitro and in vivo. Plant Pathol. 2003, 52, 60–67. [Google Scholar] [CrossRef]
- Li, Y.; Xia, L.Q.Q.; Wang, Y.N.N.; Liu, X.Y.Y.; Zhang, C.H.H.; Hu, T.L.L.; Cao, K.Q.Q. The inhibitory effect of Epicoccum nigrum strain XF1 against Phytophthora infestans. Biol. Control 2013, 67, 462–468. [Google Scholar] [CrossRef]
- Angelova, G.; Stefanova, P.; Brazkova, M.; Krastanov, A. Molecular and morphological characterization of Xylaria karsticola (Ascomycota) isolated from the fruiting body of Macrolepiota procera (Basidiomycota) from Bulgaria. PLoS ONE 2023, 18, e0287679. [Google Scholar] [CrossRef]
- Stefanova, P.; Taseva, M.; Georgieva Tz Gotcheva, V.; Angelov, A. A modified CTAB method for DNA extraction from soybean and meat products. Biotechnol. Biotechnol. Equip. 2013, 27, 3803–3810. [Google Scholar] [CrossRef]
- Toju, H.; Tanabe, A.S.; Yamamoto, S.; Sato, H. High-coverage ITS primers for the DNA-based identification of ascomycetes and basidiomycetes in environmental samples. PLoS ONE 2012, 7, e40863. [Google Scholar] [CrossRef]
- Altschul, S.F.; Gish, W.; Miller, W.; Myers, E.W.; Lipman, D.J. Basic local alignment search tool. J. Mol. Biol. 1990, 215, 403–410. [Google Scholar] [CrossRef]
- Gene Bank Database. Available online: https://www.ncbi.nlm.nih.gov (accessed on 24 September 2024).
- QIAGEN Digital Insights. Available online: https://digitalinsights.qiagen.com (accessed on 25 September 2024).
- Saitou, N.; Nei, M. The neighbor-joining method: A new method for reconstructing phylogenetic trees. Mol. Biol. Evol. 1987, 4, 406–425. [Google Scholar] [CrossRef] [PubMed]
- Bouguettoucha, A.; Balannec, B.; Amrane, A. Unstructured Models for Lactic Acid Fermentation—A Review. Food Technol. Biotechnol. 2011, 49, 3–12. [Google Scholar]
- Ibarz, A.; Augusto, P.E. An autocatalytic kinetic model for describing microbial growth during fermentation. Bioprocess. Biosyst. Eng. 2015, 38, 199–205. [Google Scholar] [CrossRef] [PubMed]
- Choi, M.; Al-Zahrani, S.M.; Lee, S.Y. Kinetic model-based feed-forward controlled fed-batch fermentation of Lactobacillus rhamnosus for the production of lactic acid from Arabic date juice. Bioprocess. Biosyst. Eng. 2014, 37, 1007–1015. [Google Scholar] [CrossRef] [PubMed]
- Kemmer, G.; Keller, S. Nonlinear least-squares data fitting in Excel spreadsheets. Nat. Protoc. 2010, 5, 267–281. [Google Scholar] [CrossRef]
- CLSI. Method for Broth Dilution Antifungal Susceptibility Testing of Filamentous Fungi, Ap-Proved Standard, 2nd ed.; CLSI document М38-А2; Clinical and Laboratory Standards Institute: Wayne, PA, USA, 2008. [Google Scholar]
- Castro, P.; Parada, R.; Corrial, C.; Mendoza, L.; Cotoras, M. Endophytic Fungi Isolated from Baccharis linearis and Echinopsis chiloensis with Antifungal Activity against Botrytis cinerea. J. Fungi 2022, 8, 197. [Google Scholar] [CrossRef]
- Abdel-Hafez, S.; Nafady, N.; Abdel-Rahim, I.; Shaltour, A.; Daros, J.; Mohamed, M. Biosynthesis of Silver Nanoparticles Using the Compound Curvularin isolated form the Endophytic Fungus Epiccocum nigrum: Characterization and Antifungal activity. J. Pharm. Appl. Chem. 2016, 3, 135–146. [Google Scholar] [CrossRef]
- Guzmán-Moreno, J.; Ramírez-Santoyo, R.M.; Ortega-Sigala, J.J.; Ángeles-Chávez, C.; Rodríguez-González, V.; Rodríguez-Serrano, C.; Patrón-Soberano, A.; de Ávila-Araiza, G.I.; Luna-Álvarez, F.; Vidales-Rodríguez, L.E. Fungal biosynthesis of gold nanoparticles with sporicidal activity against bacterial endospores. Green Chem. Lett. Rev. 2024, 17, 2360489. [Google Scholar] [CrossRef]
- El-Baky, N.A.; Abdel Rahman, R.A.; Sharaf, M.M.; Al Fattah Amara, A.A. The Development of a Phytopathogenic Fungi Control Trial: Aspergillus flavus and Aspergillus niger Infection in Jojoba Tissue Culture as a Model. Sci. World J. 2021, 1, 6639850. [Google Scholar] [CrossRef] [PubMed]
- Pieckenstain, F.; Bazzalo, M.; Roberts, A.; Ugalde, R. Epicoccum purpurascens for biocontrol of Sclerotinia head hot of sunflower. Mycol. Res. 2001, 105, 77–84. [Google Scholar] [CrossRef]
- Fernando, W.G.D.; Nakkeeran, S.; Zhang, Y. Ecofriendly methods in combating Sclerotinia sclerotiorum (Lib.) de Bary. Recent. Res. Devel Environ. Biol. 2004, 1, 329–347. [Google Scholar]
- Elmer, P.A.G.; Hoyte, S.M.; Marsden, R.; Parry, F.; Reglinski, T. Epicoccum nigrum: A biological control agent for the control of Sclerotinia sclerotiorum in New Zealand kiwifruit (Actinidia deliciosa). In The XI th International Sclerotinia Workshop; Central Science Laboratory: York, UK, 2001; 41p. [Google Scholar]
- Lee, A.J.; Cadelis, M.M.; Kim, S.H.; Swift, S.; Copp, B.R.; Villas-Boas, S.G. Epipyrone A, a Broad-Spectrum Antifungal Compound Produced by Epicoccum nigrum ICMP 19927. Molecules 2020, 25, 5997. [Google Scholar] [CrossRef]
- Pitt, J.I. Penicillium and related genera. In Food Spoilage Microorganism; Elsevier: Amsterdam, The Netherlands, 2006; pp. 437–450. [Google Scholar] [CrossRef]
- Bao, Z.; Fan, M.; Hannachi, K.; Li, T.; Zhao, J.; Li, Y.; Qian, H.; Wang, L. Antifungal activity of star anise extract against Penicillium roqueforti and Aspergillus niger for bread shelf life. Food Res. Int. 2023, 172, 113225. [Google Scholar] [CrossRef] [PubMed]
- Perrone, G.; Susca, A. Penicillium Species and Their Associated Mycotoxins. Methods Mol. Biol. 2017, 1542, 107–119. [Google Scholar] [CrossRef]
- EFSA CONTAM Panel (EFSA Panel on Contaminants in the Food Chain); Schrenk, D.; Bodin, L.; Chipman, J.K.; delMazo, J.; Grasl-Kraupp, B.; Hogstrand, C.; Hoogenboom, L.; Leblanc, J.-C.; Nebbia, C.S.; et al. Scientific Opinion on the risk assessment of ochratoxin A in food. EFSA J. 2020, 18, 6113. [Google Scholar]

| GP | MYE | MEA | YMA | |
|---|---|---|---|---|
| Glucose, g/L | 10.0 | 10.0 | - | 10.0 |
| Peptone, g/L | 10.0 | - | 3.0 | 5.0 |
| Yeast extract, g/L | 10.0 | 5.0 | - | 3.0 |
| Malt extract, g/L | 15.0 | 3.0 | 30.0 | 3.0 |
| Agar, g/L | 20.0 | 20.0 | 20.0 | 20.0 |
| Logistic Curve Model | Reversed Autocatalytic Growth Model | |||||||
|---|---|---|---|---|---|---|---|---|
| µmax, d−1 | δ, mm·d−1 | Dm, mm | R2 | k1, d−1 | k2, d−1 | K/1 + K | R2 | |
| MCM | 0.464 ± 0.087 | 0.0062 ± 0.0013 | 76 ± 2 | 0.9983 | 0.0041 ± 0.0007 | 2.1 × 10−5 ± 4.8 × 10−6 | 0.9951 ± 0.0003 | 0.9983 |
| GP | 0.475 ± 0.052 | 0.0062 ± 0.0008 | 77 ± 1 | 0.9952 | 0.0044 ± 0.0007 | 2.9 × 10−5 ± 4.9 × 10−6 | 0.9950 ± 0.0004 | 0.9972 |
| MYE | 0.408 ± 0.018 | 0.0055 ± 0.0007 | 75 ± 5 | 0.9980 | 0.0040 ± 0.0002 | 1.5 × 10−5 ± 5.1 × 10−6 | 0.9963 ± 0.0012 | 0.9983 |
| MEA | 0.495 ± 0.056 | 0.0064 ± 0.0008 | 77 ± 1 | 0.9972 | 0.0048 ± 0.0005 | 1.6 × 10−5 ± 2.4 × 10−6 | 0.9967 ± 0.0002 | 0.9985 |
| YMA | 0.442 ± 0.032 | 0.0060 ± 0.0007 | 75 ± 6 | 0.9978 | 0.0051 ± 0.0002 | 5.6 × 10−5 ± 6.2 × 10−6 | 0.9989 ± 0.0011 | 0.9970 |
| Test Microorganism | MIC, mg/mL Dry Weight |
|---|---|
| Penicillium chrysogenum | 2.5 |
| Fusarium verticillioides | - |
| Aspergillus flavus | 2.5 |
| Beauveria bassiana | - |
| Botrytis cinerea | 2.5 |
| Sclerotinia sclerotiorum | 1.25 |
Disclaimer/Publisher’s Note: The statements, opinions and data contained in all publications are solely those of the individual author(s) and contributor(s) and not of MDPI and/or the editor(s). MDPI and/or the editor(s) disclaim responsibility for any injury to people or property resulting from any ideas, methods, instructions or products referred to in the content. |
© 2024 by the authors. Licensee MDPI, Basel, Switzerland. This article is an open access article distributed under the terms and conditions of the Creative Commons Attribution (CC BY) license (https://creativecommons.org/licenses/by/4.0/).
Share and Cite
Baldzhieva, R.; Brazkova, M.; Blazheva, D.; Goranov, B.; Stefanova, P.; Ganeva, Z.; Teneva, D.; Denev, P.; Angelova, G. Growth Kinetics Modeling and Evaluation of Antiphytopathogenic Activity of Newly Isolated Fungicolous Epicoccum nigrum Associated with Dryad’s Saddle (Polyporaceae). Agriculture 2024, 14, 2179. https://doi.org/10.3390/agriculture14122179
Baldzhieva R, Brazkova M, Blazheva D, Goranov B, Stefanova P, Ganeva Z, Teneva D, Denev P, Angelova G. Growth Kinetics Modeling and Evaluation of Antiphytopathogenic Activity of Newly Isolated Fungicolous Epicoccum nigrum Associated with Dryad’s Saddle (Polyporaceae). Agriculture. 2024; 14(12):2179. https://doi.org/10.3390/agriculture14122179
Chicago/Turabian StyleBaldzhieva, Radka, Mariya Brazkova, Denica Blazheva, Bogdan Goranov, Petya Stefanova, Zlatka Ganeva, Desislava Teneva, Petko Denev, and Galena Angelova. 2024. "Growth Kinetics Modeling and Evaluation of Antiphytopathogenic Activity of Newly Isolated Fungicolous Epicoccum nigrum Associated with Dryad’s Saddle (Polyporaceae)" Agriculture 14, no. 12: 2179. https://doi.org/10.3390/agriculture14122179
APA StyleBaldzhieva, R., Brazkova, M., Blazheva, D., Goranov, B., Stefanova, P., Ganeva, Z., Teneva, D., Denev, P., & Angelova, G. (2024). Growth Kinetics Modeling and Evaluation of Antiphytopathogenic Activity of Newly Isolated Fungicolous Epicoccum nigrum Associated with Dryad’s Saddle (Polyporaceae). Agriculture, 14(12), 2179. https://doi.org/10.3390/agriculture14122179







